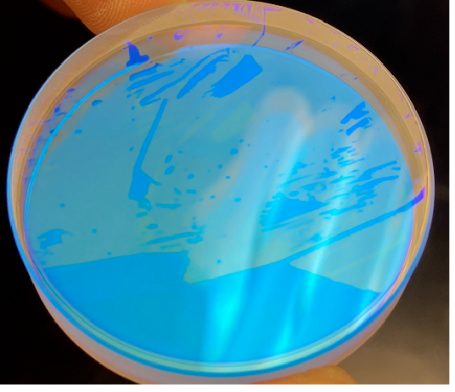

Среди аксессуаров для лазерного оборудования"нижнее защитное зеркало"является расходным материалом с очень высокой частотой замены.
Клиенты часто спрашивают, как выбрать защитное стекло. Чтобы ответить на ряд головоломок мы специально опросили инженеров Raycus по исследованиям, разработкам и послепродажному обслуживанию, чтобы задать вопросы об этих проблемах.
В1 Есть ли разница между нижними защитными зеркалами разных производителей?
Это очень большая разница. Поскольку нижнее защитное зеркало предназначено не только для защиты чистоты оптического тракта внутри режущей головки, оно также должно обладать высокой допускаемой мощностью лазера и высоким коэффициентом пропускания луча. Чтобы соответствовать этим условиям, требования к основанию, обработке, покрытию и упаковке нижнего защитного зеркала очень строгие.
Вообще говоря, цена нижнего защитного стекла, установленного в оригинальной режущей головке, выше, что также делает нижнее защитное зеркало, продаваемое третьей стороной, очень популярным, но не каждый сторонний производитель располагает производственными мощностями для таких расходных материалов.
В последние годы, когда бушует ценовая война за волоконные лазеры, цены на лазерные аксессуары становятся все ниже и ниже. Слепое стремление к низким ценам и игнорирование качества перевешивают потери.
В2 Если выбор будет неправильным, каковы будут последствия?
Последствия могут быть очень плохие, т.к. он приведет к значительному смещению фокуса, неспециализированное нижнее защитное стекло поглощает свет и выделяет тепло, что приводит к плохой резке. Сильное выделение тепла также приводит к поломке нижнего защитного зеркала и даже к обратному нарушению фокусировки и коллимации режущей головки. При повреждении дорогостоящих деталей стоимость обслуживания равна 20% -50% цены новой режущей головки. Потери огромны.
Некачественное покрытие, слабый коэффициент пропускания света слабый приведут к недостаточному пропусканию и сильному отражению, что может привести к тому, что обратный свет нижнего защитного зеркала пройдет через коллиматор режущей головки и зеркало фокусировки в обратном направлении и вновь сойдется у торцевой крышки выходной головки, вызывая сгорание защитного колпачка оптоволокна.
Более серьезная ситуация заключается в том, что при сгорании торцевой крышки выхода головки прямой луч не может передаваться и заглушается в выходной головке, что непосредственно приводит к разрушению металлической конструкции выходной головки, утечке воды, разбрызгиванию шлака и другим явлениям. В этом случае это, как правило, приводит к необратимому повреждению режущей головки.
В3 Как выбрать защитное стекло?
Вообще говоря, для мелких и средних конечных потребителей спрос на расходные материалы относительно невелик. Их можно приобрести через каналы поставщиков оборудования.
По неофициальным каналам или при значительных разницах в цене вам необходимо совершать покупки с осторожностью.
При большом спросе, сильных позиций на переговорах и возможностей контроля качества могут приобретаться у интеграторов, производителей расходных материалов или агентов первого уровня.
При покупке следующего защитного зеркала вы можете выполнить отбор в соответствии со следующими пунктами:
Основа: Выбирайте более совершенные материалы в отрасли.
Производители: Старайтесь выбирать производителей оптической холодной обработки, обладающих квалификацией в области производства мощных лазерных стекол, линз и других оптических деталей.
Покрытие: Необходима просветляющая пленка в соответствии с длиной волны лазерного излучения.
Протокол испытаний: запросите отчет о длине волны пропускания защитного зеркала, отчет о качественной отделке, модель материала, отчет о слабом поглощении (не требуется), отчет об адгезии покрытия, отчет о размере и форме и т.д.
В4 Какое защитное зеркало нельзя использовать?
Существует четыре вида защитных зеркал, которые нельзя использовать. Одно из них - это зеркало с открытой поверхностью покрытия. Этот вид защитного зеркала можно распознать невооруженным глазом:
Второе - это защитное зеркало с плохим качеством покрытия. Внешний вид этого защитного зеркала правильный, но при проверке пропускание некоторых участков покрытия низкое, а отражение высокое. Этот тип защитного зеркала невозможно распознать невооруженным глазом и в микроскоп, и его можно измерить только профессиональными приборами:
Третье - защитное зеркало с посторонними предметами или пузырьками воздуха между слоем пленки и подложкой. Этот тип стекол используется при высокой мощности, имеет короткий срок службы и очень легко поддается обжигу:
Четвертый вид защитного зеркала с плохой отделкой.Такой срок службы слишком короток:
В05
Как судить о ненормальности нижнего защитного зеркала?
Как точно определить нестабильность системы и риски, вызванные ненормальной защитой от отключения, является насущной необходимостью на рынке резки.
В настоящее время большинство мощных режущих головок имеют функцию контроля температуры защитного зеркала и рассеянного света, но некоторые виды контроля режущих головок косвенно зависят от текущей температуры, что не позволяет достичь высокой точности и чувствительности отклика.
В связи с вышеизложенной ситуацией,Компания Raycus полностью внедрила новый тип системы контроля отраженного света в лазерах средней и высокой мощности.
Наиболее важный датчик контроля обратного света встроен рядом с торцевой крышкой выходного оптического кабеля, образуя приблизительный коаксиальный контроль. При повреждении оптического элемента в режущей головке и появлении обратного света на него можно быстро отреагировать.
При условии обеспечения нормальной работы системы водяного охлаждения обратный оптический мониторинг лазеров Raycus быстро посылает сигналы тревоги при соблюдении следующих трех условий: (1) нижнее защитное зеркало ненормально; (2) верхнее защитное зеркало ненормально; (3) обработка материалов с высокой отражающей способностью.
На примере модели Raycus мощностью 20 кВт с 2019 года был внедрен мониторинг обратного излучения, позволяющий успешно избежать следующих проблем:
- Определение неразборчивого использование клиентом и защита его в ненадлежащих условиях, чтобы избежать повреждения выхода оптокабеля;
- Определение плохой конструкции производителя режущей головки;
- Установление, что режущая головка заказчика находится в плохом состоянии;
Качество защитных линз на современном рынке неодинаково. При покупке рекомендуется тщательно проверять в соответствии с вышеуказанным содержанием и приобретать через официальные каналы.